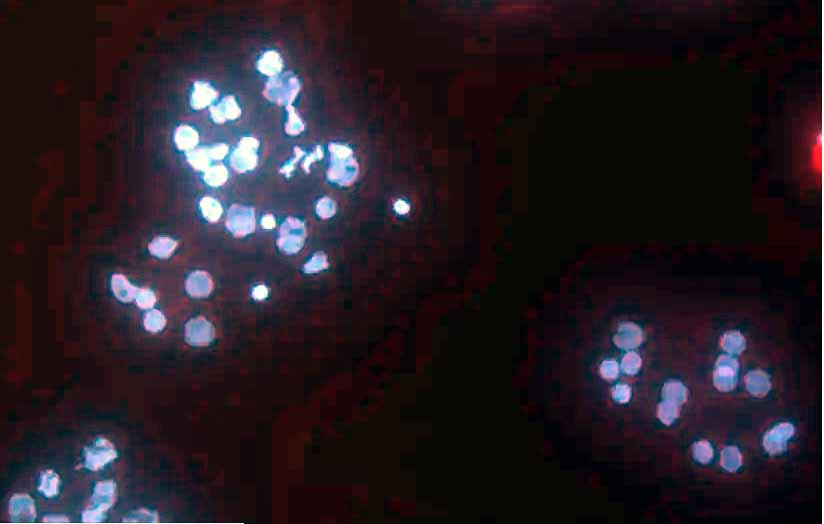

Theo một nghiên cứu công bố trên Proceedings of the National Academy of Sciences of the United States of America (Kỷ yếu Hàn lâm Viện Quốc gia Khoa học Mỹ), nhóm nghiên cứu do giáo sư Dorothee Huchon dẫn đầu đã mô tả chi tiết cơ thể sống có đặc điểm kỳ lạ này.
Đó là một sinh vật mang tên Henneguya salminicola chỉ gồm 10 tế bào sống ký sinh trong cơ của cá hồi.
Phát hiện được cho là tình cờ khi nghiên cứu bản chất của nhóm sinh vật kỵ khí vốn có đặc điểm sử dụng rất ít dưỡng khí. Con ký sinh trùng mới lộ diện tuyệt nhiên không dùng bất cứ nguồn oxygen nào.
Các nhà nghiên cứu nhận thấy cấu trúc cơ thể của nó không có mitochondrial genome, hệ gene được xem như một kiểu nhà máy điện của tế bào nơi các phân tử oxygen từ không khí được đưa vào để sản xuất năng lượng.
“Sự vắng mặt genome ấy cho thấy con vật không có oxygen để thở”, giáo sư Huchon nhận định. Sinh vật này bước đầu được cho là dạng “trung gian tương đối” giữa sứa và san hô.
Đặc biệt, người ta xác định nó chắc chắn không cần thở và không tiêu thụ oxygen để sản xuất năng lượng.
Phát hiện gây sốc cho các nhà tiến hoá khi học thuyết tiến hoá luôn tin rằng động vật phải ăn oxygen mới sinh tồn được.
“Hô hấp kỵ khí thường được thực hiện bởi toàn thân của động vật song bây giờ chúng tôi dám chắc quan điểm ấy không còn đứng vững nữa”, Huchon giải thích.
“Phát hiện của chúng tôi cho thấy tiến hoá có thể đi theo các hướng khác lạ. Hô hấp kỵ khí từng được coi là nguồn năng lượng chủ yếu và giờ đây chúng tôi nhận thấy con vật đã từ bỏ cách thức then chốt này”.
Câu hỏi thú vị đặt ra là làm thế nào con ký sinh trùng kia lấy năng lượng để tồn tại nếu nó không thở.










